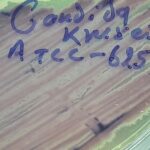
Pichia kudriavzevii ATCC strain on HiCrome Candida differential agar

Tag: ITS sequencing
Pichia kudriavzevii-Introduction, Morphology, Pathogenicity, Lab Diagnosis, Treatment, Prevention, and Keynotes
 Introduction Pichia kudriavzevii, formerly known as Candida krusei, is a unique budding...
Introduction Pichia kudriavzevii, formerly known as Candida krusei, is a unique budding...
Introduction Pichia kudriavzevii, formerly known as Candida krusei, is a unique budding...
Introduction Pichia kudriavzevii, formerly known as Candida krusei, is a unique budding...